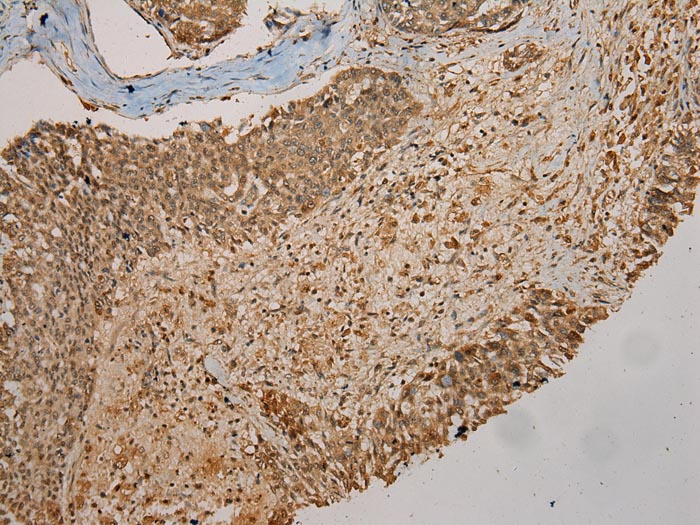

-
分类: 科研抗体货号: P43439别名: GLO2; GLX2; GLXII; HAGH1应用: WB,IHC反应种属: Human
-
分类: 科研抗体货号: P43423别名: FGH应用: WB,IHC反应种属: Human,Mouse
-
分类: 科研抗体货号: P43433别名: PPD; 4HPPD; GLOD3; 4-HPPD; HPPDASE应用: WB,IHC反应种属: Human,Mouse
-
分类: 科研抗体货号: P43438别名: PIG2; CCDS2; TP53I2; HEL-S-20应用: WB,IHC反应种属: Human
-
分类: 科研抗体货号: P43422别名: p100; TDRD11应用: WB,IHC反应种属: Human,Mouse
-
分类: 科研抗体货号: P43432别名: ACS; ACSA; ACAS2; ACECS; dJ1161H23.1应用: WB,IHC反应种属: Human
-
分类: 科研抗体货号: P43437别名: SDR1E1应用: WB,IHC反应种属: Human
-
分类: 科研抗体货号: P43421别名: PAP; PDCD9; S30mt; MRP-S30应用: WB,IHC反应种属: Human
-
分类: 科研抗体货号: P43431别名: p17; YBL1; CHRAC17; CHARAC17应用: WB,IHC反应种属: Human
-
分类: 科研抗体货号: P43436别名: TRIP1; EIF3S2; TRIP-1; PRO2242; eIF3-p36; eIF3-beta应用: WB,IHC反应种属: Human

鄂公网安备42018502007531号
鄂公网安备42018502007531号

